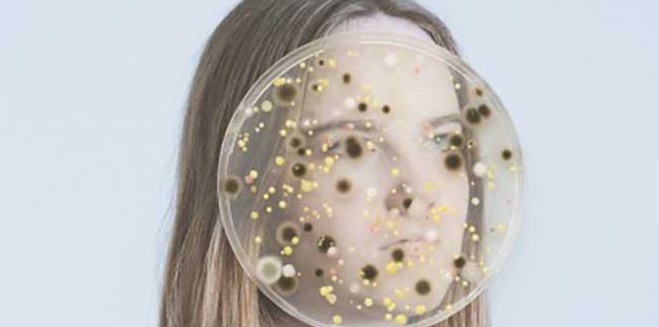

Состав микрофлоры кишечника при болезни паркинсона
Доказано нарушение состава и функций кишечной микрофлоры при болезни Паркинсона
Болезнь Паркинсона (БП) является прогрессирующим нейродегенеративным заболеванием. Несмотря на его распространенность, лечение и профилактика БП в настоящее время разработаны недостаточно хорошо.
В 2003 году Хейко Браак впервые предположил, что ненаследственные формы БП вызваны некоторыми патогенными бактериями в кишечнике. Согласно его гипотезе, патоген способен проникать через слизистую оболочку кишечника и достигать головного мозга сквозь гемато-энцефалический барьер. Тем не менее, до настоящего времени не было никаких доказательств существования патогенных микроорганизмов или продуцируемых ими молекул, вызывающих БП.
Недавняя публикация в журнале Parkinson's Disease открыла новую главу в изучении связи кишечного микробиома с развитием БП. Ученые из Университета Алабамы в Бирмингеме (США) сообщили об избыточном скоплении оппортунистических бактерий в кишечнике пациентов с БП по сравнению с людьми из контрольной группы. Оппортунистические бактерии обычно безвредны для здорового человека, но их численность может возрастать при иммунодефиците и других состояниях, связанных с нарушением иммунитета. В таком случае указанные бактерии превращаются в патогенных.
Ученые выполнили крупнейшее на сегодняшний день исследование по оценке взаимосвязи изменений микробиома с БП. Для этого были проанализированы данные предыдущих экспериментов, в частности исследование 2017 года, в котором было 197 пациентов с БП и 130 здоровых людей, с применением новой, более точной технологии в области биоинформатики. Они также провели новый независимый набор данных с включением 323 пациентов, страдающих БП и 184 здоровых добровольцев.
При обработке данных исследователи применили для определения микробных сообществ сетевой анализ. Понятным примером сетевого анализа служит Facebook, где можно сопоставить связи между подписчиками или друзьями. У нескольких людей будет огромное количество связей, у некоторых будет много, а у подавляющего большинства их будет гораздо меньше. Карта этих соединений похожа на карту маршрутов самолетов разных авиакомпаний.
Исследователи подчеркивают, что нельзя судить о функции оппортунистической микрофлоры, основываясь лишь на факте взаимосвязи с БП.
Используя анализ сети, Паями и коллеги обнаружили три микробных кластера, каждый их которых имеет общие функциональные характеристики. Первый кластер был скоплением оппортунистических бактерий, в избытке наблюдаемых при БП, что ранее было неизвестно.
Два других кластера содержали бактерии, обнаруженные в предыдущих исследованиях. В сравнении с контрольной группой у пациентов с БП отмечено снижение доли микробов, которые производят короткоцепочечные жирные кислоты. В третьем кластере среди пациентов с БП преобладали бактерии, метаболизирующие углеводы, в сравнении со здоровыми людьми. Дальнейшие эксперименты помогут определить, какую роль они играют при нейродегенеративных заболеваниях.
Согласно анализу данных, изменения микрофлоры кишечника не зависели от пола, возраста, массы тела, нарушения стула, желудочно-кишечного дискомфорта, места жительства и диеты пациентов.
Ученые заключили, что предстоит детализировать полученные результаты в исследованиях с использованием большим числом участников. Это нужно для отслеживания изменений микрофлоры от скрытой до прогрессирующей фазы заболевания. Новые технологии секвенирования генома бактерий позволят лучше понять функции бактерий, археев, грибов и даже вирусов.
Кишечная микрофлора, действуя через иммунную систему мозга, ускоряет в нём нейродегенеративные процессы.
Влияние кишечной микрофлоры на нашу жизнь давно стало общепризнанным – симбиотические бактерии не просто помогают нам переваривать пищу, они также довольно сильно влияют на обмен веществ в целом (некоторые из них, например, снижают вероятность диабета, некоторые, наоборот, повышают); микробы регулируют некоторые функции иммунитета и даже вмешиваются в работу нервной системы. Но далеко не всегда микробы и хозяин живут в мире и согласии – бывает так, что отношения между иммунной системой и микрофлорой портятся, из-за чего в организме начинается вялотекущее воспаление, которое, в свою очередь, может навредить мозгу.
Какой же вред для мозга может произойти из-за кишечных микробов? Известно, что болезнь Паркинсона часто сопровождается пищеварительными проблемами, которые проявляются порой задолго до неврологических симптомов. Также известно, что у больных с паркинсонизмом состав микрофлоры иной, нежели у здоровых людей.
Тимоти Сэмпсон (Timothy Sampson) из Калифорнийского технологического института и его коллеги решили более детально выяснить, как связаны бактерии в кишечнике и синдром Паркинсона. Для этого использовали генетически модифицированных мышей, у которых активно синтезировался человеческий патогенный альфа-синуклеин. Напомним, что нейродегенеративные заболевания (болезни Паркинсона, Альцгеймера, Хантингтона и целый ряд других) возникают оттого, что в нейронах мозга накапливаются большие белковые комплексы, токсичные для нервных клеток. Изначально такие белки безвредны и нужны клеткам для каких-то функций, однако после определённых модификаций молекулы нейродегенеративных белков становятся опасными, начиная слипаться друг с другом в вышеупомянутые токсичные комплексы.
У каждого такого заболевания – свои патогенные белки; если мы говорим про болезнь Паркинсона, то в её случае обычно вспоминают про белок под названием альфа-синуклеин. И, если мы снабдим мышь патогенной формой синуклеина, или просто заставим организм синтезировать его в очень большом количестве, то у животного проявятся характерные симптомы болезни Паркинсона – тремор, неспособность контролировать собственные движения, неспособность удерживать равновесие тела и, среди прочего, проблемы с кишечной перистальтикой.
Именно таких мышей использовали и на этот раз, только некоторые из них жили, как обычно живут лабораторные мыши, а некоторых росли в стерильных условиях; были и такие, которым давали антибиотики, искореняющие желудочно-кишечных микробов. В статье в Cell авторы пишут, что животные, лишённые кишечных бактерий, лучше двигались, и их пищеварительный такт тоже чувствовал себя лучше, чем у тех, у которых внутри была обычная микрофлора. Более того, у безбактериальных мышей в мозге появлялось меньше характерных паркинсонных белковых отложений.
С другой стороны, при наличии бактерий заметно усиливались воспалительные процессы в мозге (а воспаление, как считается, может помогать и нейродегенеративным заболеваниям в том числе). Живя в кишечнике, бактерии выделяют короткие жирные кислоты (вроде уксусной или масляной), один из продуктов их обмена веществ – и вот, когда такие кислоты вводили мышам, лишённым бактерий, то у них становились слишком активными клетки микроглии, выполняющие в мозге иммунные функции, быстрее возникали альфа-синуклеиновые отложения и быстрее развивались симптомы паркинсонизма. То есть можно восстановить следующую цепочку событий: бактерии в кишечнике выделяют свои жирные кислоты, на которые реагирует иммунная система, далее развивается воспалительная реакция, которая стимулирует паркинсонные процессы в мозге.
Напомним, что совсем недавно мы рассказывали о том, как болезнь Паркинсона может в буквальном смысле прийти в мозг из кишечника: патогенные синуклеиновые комплексы способны формироваться в клетках пищеварительного тракта, после чего поднимаются оттуда в мозг по блуждающему нерву. Вполне возможно, что и описанный воспалительный механизм, и путешествие синуклеина по нервам как-то связаны друг с другом, однако вместо предположений тут лучше подождать новых исследований на эту тему.
В последние годы исследователи обнаружили, что микробиом влияет на наше здоровье. Теперь ученые впервые исследовали, как кишечные микробы могут играть ключевую роль в развитии болезни Паркинсона. Результаты исследования опубликованы в научном журнале Cell .
(с) Wellcome Images/Samuel Kaye
Актуальность проблемы
Десятки триллионов микроорганизмов живут в нашем кишечнике и содержат, по меньшей мере, 1000 видов бактерий и более 3 миллионов генов. В то время как одна треть кишечных микробов являются общими для большинства людей, остальные две трети являются специфическими для каждого из нас. Они развиваются в течение всей жизни, в зависимости от диеты, образа жизни и воздействия окружающей среды.
Все чаще исследователи изучают, как изменения микробиома влияют на общее состояние здоровья. Они обнаружили, что изменение микрофлоры кишечника может вызвать ожирение и рак, а также влияет на головной мозг, в том числе может привести к аутизму, тревоге и депрессии.
Предыдущие исследования выявили, что в микробиоме кишечника у пациентов с болезнью Паркинсона происходят изменения, эти люди часто испытывают запоры и другие проблемы желудочно-кишечного тракта за несколько лет до появления первых симптомов заболевания.
Материалы и методы исследования
В новом исследовании ученые использовали мышей, у которых был генетически модифицирован белок под названием альфа-синуклеин. Распространено мнение, что он влияет на развитие болезни Паркинсона. В результате у грызунов появились двигательные симптомы и агрегация альфа-синуклеина, характерные для этого заболевания.
Некоторые из мышей были стерильны; они содержались в стерильной среде. Остальные мыши были выведены в нормальной среде и имели множество сложных кишечных микробов.
Результаты научной работы
Когда в обеих группах мышей проводили испытание их двигательных навыков, ученые обнаружили, что стерильные мыши задание выполняли гораздо лучше, чем мыши с кишечными микробами.
Затем стерильным мышам ученые пересадили микробы кишечника либо от здорового человека, либо от пациента с болезнью Паркинсона. У мышей с трансплантированными микробами от пациентов с болезнью Паркинсона стали проявляться симптомы болезни, в том числе проблемы с движением, агрегация альфа-синуклеина и воспаление, в то время как у мышей, получавших микробы от здоровых людей, признаков заболевания не было. Кроме того, исследователи обнаружили, что у стерильных мышей с симптомами Паркинсона были обнаружены высокие уровни короткоцепочечных жирных кислот в их фекалиях. Исследователи вполне уверены, что кишечные бактерии регулируют симптомы болезни Паркинсона.
Предыдущие исследования показали, что альфа-синуклеин вызывает иммунную реакцию в головном мозге. Таким образом, ученые полагают, что дисбаланс альфа-синуклеина приводит к воспалению мозга. Это может привести к повреждению и гибели нервных клеток, вызывая симптомы болезни Паркинсона.
Новое исследование показывает, что микробиом кишечника может сыграть решающую роль при болезни Паркинсона. Эти результаты могут приблизить к новым методам лечения болезни Паркинсона, возможно, в виде пробиотиков или пребиотиков. Исследователи говорят, что в первую очередь необходимо определить, какие именно кишечные микробы могут способствовать болезни Паркинсона.
Литература
Понравилась новость? Читайте нас в Facebook

Приглашаем подписаться на наш канал в Яндекс Дзен
Исследователям из Калифорнийского технологического института (California Institute of Technology) впервые удалось обнаружить связь между бактериями, населяющими кишечник, и болезнью Паркинсона. Исследователи продемонстрировали, что изменения в популяции микроорганизмов — или, возможно, сами кишечные бактерии — вносят существенный вклад в развитие двигательных нарушений, характерных для болезни Паркинсона, или даже являются причиной возникновения этих нарушений.
Результаты работы были опубликованы 1 декабря в издании Cell.
Болезнью Паркинсона страдают около 10 млн людей во всем мире. Признаки заболевания включают тремор и трудности при ходьбе, накопление белка альфа-синуклеина (SNCA, αSyn) в клетках мозга и кишечника и присутствие провоспалительных цитокинов в мозге. 75 % пациентов с болезнью Паркинсона также страдают нарушениями работы ЖКТ, чаще всего, запорами.
Чтобы проверить эту гипотезу, учёные использовали мышей с повышенной выработкой альфа-синуклеина, белка, связанного с развитием болезни Паркинсона. В кишечнике одной группы мышей присутствовали различные бактерии, образующие сложное сообщество. Другая группа мышей, выращенная в стерильных условиях, была лишена микробиоты. Исследователи изучили движения мышей в ходе выполнения разных тестов: мыши бегали в колесе, перемещались по мостику и спускались по жёрдочке. Животные, у которых микрофлора отсутствовала, демонстрировали существенно лучшие результаты, чем те, у которых она имелась.
«Это и был момент открытия, — рассказывает один из авторов работы Тимоти Сампсон (Timothy Sampson), аспирант факультета биологии и биоинженерии. — Мыши были генетически идентичны, организмы животных в обеих группах синтезировали слишком много альфа-синуклеина. Отличались группы только наличием микробиоты. В её отсутствие мыши сохраняли способность нормально двигаться даже в условиях избытка альфа-синуклеина.
Когда бактерии кишечника расщепляют клетчатку, они вырабатывают молекулы короткоцепочечных жирных кислот (КЦЖК), например, уксусной или масляной. В предыдущих исследованиях было показано, что эти молекулы могут активировать иммунный ответ в головном мозге. Поэтому группа учёных под руководством Мазманяна предположила, что причиной развития воспалительного процесса в головном мозге и других признаков болезни Паркинсона может являться дисбаланс выработки КЦЖК. Когда мышам, лишённым микробиоты, давали КЦЖК с пищей, у них наблюдалась активация микроглии, иммунных клеток, присутствующих в мозге. Это воспаление могло привести к нарушению работы нейронов и даже к их гибели. Действительно, у мышей, получавших КЦЖК, развились симптомы болезни Паркинсона, а в участках головного мозга, связанных с заболеванием, теперь накапливался альфа-синуклеин.
В заключительной серии экспериментов учёные объединились с Али Кешаварзяном (Ali Keshavarzian), гастроэнтерологом из Университета Раш (Rush University), чтобы получить образцы фекалий пациентов, страдающих болезнью Паркинсона, и образцы из контрольной группы. Человеческая микрофлора была подсажена мышам, не имевшим собственных бактерий. После процедуры у мышей, получивших бактерии пациентов с болезнью Паркинсона, развились симптомы заболевания, кроме того, в их фекалиях были обнаружены высокие уровни КЦЖК. У мышей, которым были введены бактерии людей из контрольной группы, признаки болезни не обнаруживались.
Результаты исследования важны для лечения болезни Паркинсона, утверждают авторы работы.

Это удалось установить ученым одного из институтов в Калифорнии (США) в экспериментах на мышах с болезнью Паркинсона.
Они показали, что здоровые микробы кишечника уменьшают симптомы этого заболевания.
Что такое болезнь Паркинсона?
1. Болезнь Паркинсона (БП) является хроническим и прогрессирующим расстройством движения, а это означает, что симптомы продолжаются и ухудшаются с течением времени.
2. Почти один миллион людей в США живут с болезнью Паркинсона.
3. Причина неизвестна, и, хотя в настоящее время нет лечения, есть варианты лечения, такие как лекарства и операции, чтобы управлять своими симптомами.
4. Болезнь Паркинсона включает неисправности и гибель жизненно важных нервных клеток в головном мозге, называемых нейронами.
5. При болезни Паркинсона в первую очередь страдают нейроны в области мозга, называемой черной субстанцией.
6. Некоторые из этих умирающих нейронов производят допамин, химическое вещество, которое посылает сообщения в часть мозга, которая контролирует движение и координацию.
7. По мере развития БП, количество дофамина, вырабатываемого в мозге, уменьшается, в результате чего человек приобретает не двигательные симптомы болезни Паркинсона, которые включают в себя следующее:
- тремор рук, руки, ноги, челюсти и лица,
- брадикинезия или замедленность в состоянии контролировать движение нормально.
8. Конкретная группа симптомов, которые индивид испытывает, варьируется от человека к человеку.
9. Основные нарушения движений:
- жесткость или жесткость конечностей и туловища,
- постуральная нестабильность или нарушение равновесия и координации
Болезнь развивается постепенно, часто начинается с едва заметного тремора, скованностью и замедлением движения.
Однако по мере прогрессирования заболевания симптомы нарастают, и моторные навыки становятся все более ослабленными.
Лечение болезни Паркинсона – это восстановление здоровой микрофлоры кишечника.
1. Исследование было опубликовано в одном из популярных научных журналов, и оно создало потенциальный сдвиг парадигмы в лечении болезни Паркинсона.
2. То есть выводы этого исследования идут вразрез с существовавшим ранее убеждением в научном медицинском сообществе, что причины Паркинсона локализуются в головном мозге и нервной системе.
3. Ведь болезнь Паркинсона в настоящее время является вторым наиболее распространенным нейродегенеративным заболеванием в США. Им страдают около одного миллиона человек.
4. Микробы кишечника и преимущества пробиотиков уже получили немного гласности в последнее время.
Но это исследование, несомненно, ускорит дискуссии о пользе пробиотиков.
5. Лечение болезни Паркинсона на уровне кишечника представляет собой настоящий сдвиг парадигмы в том, как прогрессирующее заболевание нервной системы должно рассматриваться и лечиться, говорят исследователи.
6. Новые возможности теперь доступны для того, чтобы не считать это заболевание необратимым и неизлечимым.
7. При болезни Паркинсона страдает не только мозг, но и отмечаются расстройства нервной системы.
8. Болезнь Паркинсона обусловлена накоплением аномально сформированных белков в нейронах головного мозга.
9. Это, в свою очередь, вызывает токсические эффекты в клетках, ответственных за выпуск допамина в областях мозга, связанные с движением и управлением движения.
10. Пациенты начинают испытывать тремор, ригидность мышц, и нарушение движения, что становится хуже с течением времени.
11. Лечение болезни Паркинсона были сосредоточены на повышении уровня допамина в головном мозге.
12. Тем не менее, эти процедуры, как правило, теряют свою эффективность с течением времени, а также могут вызвать ряд неприятных побочных эффектов.
13. У пациентов, страдающих болезнью Паркинсона, были обнаружены изменения в составе микробиома в кишечнике.
14 .Они также могут иметь желудочно-кишечные проблемы, которые могут предшествовать или сопровождать более общие симптомы болезни Паркинсона.
15. Преимущества пробиотиков теперь включают пониженный риск развития болезни Паркинсона
16. Здоровый уровень полезных микробов в кишечнике уже связан с положительным нейронным развитием и здоровыми познавательными способностями.
17. Напротив, проблемы со здоровьем кишечника были связаны с мозгом и проблемами с настроением, включая депрессию, тревожность и аутизм.
18. Это недавнее исследование проливает свет на роль кишечного микробиома в предотвращении нейродегенеративных заболеваний, таких как болезнь Паркинсона.
Конечно, больше исследований должно быть сделано, чтобы идентифицировать специфические метаболиты, связанные с болезнью Паркинсона.
Однако уже сейчас принятие мер для улучшения здоровья кишечника является хорошей идеей не только для предотвращения, но и для облегчения состояния больных Паркинсоном.
Перечень преимуществ пробиотиков продолжает расти дальше, и пониженный риск болезни Паркинсона является весьма убедительным.
Некоторые из лучших источников пищи пробиотиков включают йогурт и ферментированные продукты, такие как соленые огурцы, квашеную капусту, мисо суп, кефир, чайный гриб, темпех и кимчи.
И, наконец, есть много органических, сырых фруктов и овощей, которые имеет решающее значение для здоровья кишечника.
Эта статья может быть полезна тем, у кого нет болезни Паркинсона, но есть или были у их родственников, для принятия мер по профилактике этого заболевания.
Вы можете помочь большому числу больных Паркинсоном, если нажмете на кнопки социальных сетей.
А мне будет приятно, если вы дадите оценку этой статьи, нажав на звездочки внизу статьи.
Каждая звездочка соответствует оценке от 1 до 5 (по порядку их расположения от 1-ой до 5-ой).
За последние годы, многие научные исследования посвящены информации о микробиоме кишечника и как он может влиять на здоровье. Впервые ученые выявили, что влияние микрофлоры на болезнь Паркинсона может быть ключевым.

Ученые полагают, что микробиом играет важную роль в болезни Паркинсона.
В статье, опубликованной в журнале Cell, исследователи продемонстрировали как изменения в кишечной флоре у мышей, модифицированных под модель болезни Паркинсона, приводит к патологическим изменениям в мозгу и моторному дефициту характеристик болезни (модифицированные мыши – это зверьки с генетически заложенной предрасположенностью к тому или иному заболеванию).
Ученые утверждают, что их находки смогут приблизить научное сообщество к новым методам лечения болезни Паркинсона – прогрессирующему расстройству двигательной активности, которой только в Америке подвержено около 1 миллиона граждан.
Впервые определена биологическая связь между болезнью и микробиотой. В целом, исследование выявило, что нейродегенеративная болезнь возможно берет свое начало в кишечнике, а не только в мозге.
Кишечный микробиом и здоровье
Десятки миллиардов микроорганизмов живут в нашем кишечнике, представляя более 1000 видов бактерий и более 3 миллионов генов.
В то время как одна треть состава микрофлоры является одинаковой у всех людей, оставшиеся две трети специфичны для каждого индивидуума. Микробиом претерпевает изменения на протяжении всей жизни человека и зависит от образа жизни, питания, других привычек человека и окружающей среды.
Все больше ученые узнают, как изменения микробиоты отражается на общем здоровье и риске развития заболеваний. Определена зависимость от микробиоты таких состояний как ожирение, рак, аутизм, тревожный невроз, депрессия.
Новое исследование показало, как микрофлора кишечника может быть вовлечена в болезнь Паркинсона.
Прежние исследования определили, что за несколько лет до клинических проявлений болезни Паркинсона, больные имели определенные изменения состава микрофлоры и часто испытывали запоры и другие проблемы с ЖКТ.
Примечательно, что 70% всех нейронов периферической нервной системы находятся не в голове или спинном мозге, а в стенках кишечника и все они напрямую взаимодействуют с центральной нервной системой через вагусный нерв.
Так как проблемы ЖКТ часто предшествуют проблемам моторных функций, и большинство причин болезни Паркинсона связаны с факторами окружающей среды, ученые предположили, что микробиом может играть роль в развитие болезни Паркинсона.
Моторные функции сохраняются лучше в мышах со стерильным кишечником
Что бы проверить свое предположение, ученые использовали мышей генетически модифицированных вырабатывать альфа-синуклеин, белок, который признается патогенетическим фактором в развитии Паркинсона. Эти грызуны рано проявляют моторные симптомы и агрегацию альфа-синуклеина как характеристики болезни.
Часть мышей была выращена в полностью стерильных условиях, что выражалось в очень бедном представительстве микробиома. Другие мыши были с нормальной флорой.
При тестировании моторных функций было выявлено, что свободные от микрофлоры кишечника мыши справлялись с заданиями гораздо лучше.
Генетически все мыши были идентичны, обе группы продуцировали одинаково альфа-синуклеин. Единственная разница состояла в том, что одна группа имела практически стерильный кишечник. Именно эта группа, несмотря на высокую продукцию альфа-синуклеина демонстрировала нормальные моторные функции.
Причастность микрофлоры в развитие болезни не вызывает сомнения, ученые хотят знать как это происходит.
Микробы кишечника от больных болезнью Паркинсона провоцирует симптомы болезни у мышей
Следующим этапом стала трансплантация мышам из группы с отсутствием микрофлоры микробиоты от взрослых людей, здоровых или больных болезнью Паркинсона.
Мыши, получившие трансплантат из кишечника больных болезнью Паркинсона начинали проявлять симптоматику заболевания, включая моторные нарушения и агрегацию альфа-синуклеина, а так же характерный воспалительный процесс. При получении микрофлоры от здоровых людей, мыши оставались здоровыми.
Дополнительно было отмечено, что мыши свободные от микрофлоры кишечника, и получившие трансплантат от больных болезнью Паркинсона в составе кала имели высокое содержание коротко-цепочных жирных кислот. Эти кислоты продуцируются микрофлорой и, как показали прежние исследования, запускают иммунные процессы в мозге и несбалансированность их содержания вызывает воспаление мозговой ткани. Это ведет к повреждению и смерти клеток мозга.
Таким образом, ученые делают вывод, что микрофлора играет ключевую роль в развитии болезни Паркинсона, и отрицают традиционную концепцию, что эта болезнь исключительно проблема мозга.
Авторы исследования соглашаются с тем, что данная патология многофакторная и имеет несколько генетических предиспозиций и факторов окружающей среды в качестве триггерных. Факт, что причина скрывается не только в мозге, но и кишечнике радикально новый подход в нейронауке.
Ученым предстоит ответить на вопрос, какие конкретно штаммы микроорганизмов вызывают развитие болезни Паркинсона. Они не сомневаются, что это даст толчок к поиску принципиально новых подходов к методам лечения. Возможно, что ответ будет найден в форме пробиотиков или пребиотиков, применение которых может быть намного эффективнее и безопаснее современных методов лечения.
Следствием болезни Паркинсона является не только длительный прием медикаментозных средств, но и соблюдение специальной диеты. Питание при болезни Паркинсона должно быть сбалансированным, полноценным и способствовать скорейшему восстановлению нейронных взаимосвязей.
Правильно составленное меню снижает выраженность проявления функциональных и вегетативных последствий болезни.
Сбалансированное питание положительно влияет на состояние здоровья при болезни Паркинсона
Основные принципы диеты при Паркинсоне
Сбалансированное питание при дегенеративном поражении головного мозга справляется сразу с несколькими задачами. Подход помогает бороться с ожирением и повышенным холестерином, способным привести к атеросклерозу. Он насыщает организм витаминами и минералами для нормального течения химических реакций и обменных процессов. Правильно составленное меню способствует ускоренному выведению из тканей токсинов, насыщению их антиоксидантами.
Базовые правила диеты при болезни Паркинсона:
В Интернете можно найти отзывы людей с болезнью Паркинсона, которые ссылаются на положительный эффект от лечебного голодания. Метод подразумевает воздержание от пищи в течение 5-7 дней с последующим серьезным ограничением состава рациона еще на 30-40 дней. Некоторые врачи подтверждают эффективность подхода, указывая на уменьшение после него выраженности симптомов и активацию работы мозга.
Большинство специалистов все же рекомендует воздерживаться от таких радикальных подходов. Ученые считают, что эти эксперименты могут оказаться губительными для истощенного организма.
Отказ от полноценного питания грозит ухудшением общего состояния пациента, усугублением клинической картины, появлением дополнительных проблем.
Регулярное проведение разгрузочных дней стимулирует работу мозга, укрепляет память, запускает синтез нейротропных протеинов и новых нервных клеток, повышает интеллект. Оптимальным для таких мероприятий считается суточный объем в 600 ккал, но этот показатель может быть скорректирован лечащим врачом. Частоту проведения сеансов также устанавливает невролог. Во время разгрузочных дней рекомендуется воздержаться от повышенной физической или умственной активности. В этом случае дефицит калорий доставит минимум дискомфорта, не вызовет негативных последствий.
Что кроется под этим диагнозом
Болезнь Паркинсона мучительная, разрушающая личность и неизлечимая. Терапия лишь поможет замедлить процесс и сгладить симптомы. Причина заболевания кроется в том, что начинают гибнуть клетки черной субстанции мозга. В нормальном состоянии черное вещество вырабатывает дофамин – гормон, который помогает передаче нервных импульсов, ответственных за управление мелкой моторикой.
У больного Паркинсоном вырабатывается крайне мало столь нужного дофамина. Именно по этой причине развивается характерное дрожание головы, рук. Чаще всего от этой патологии страдают пожилые люди.
Пока нет лекарств, способных порадовать больных и врачей устойчивым эффектом. У используемых препаратов есть множество побочных действий. Потому ведутся постоянные поиски альтернативы медикаментам. Одна из них – правильное питание.
Разрешенные продукты
Разрабатывая принципы питания и составляя меню при болезни Паркинсона, можно использовать практически все натуральные продукты. Это позволяет делать рацион больного полноценным и разнообразным. Серьезные ограничения необходимы только в частных случаях на фоне индивидуальных особенностей состояния.
Продукты, полезные при болезни Паркинсона:
- белая морская рыба и морепродукты, желательно в замороженном или охлажденном виде, а не в качестве копченостей;
- овощи – по возможности свежие, хорошо измельченные. Также полезны овощные супы-пюре;
- ягоды и фрукты также в свежем виде или в качестве компотов, приготовленных из замороженных ингредиентов;
- источники натуральной клетчатки – семена льна и кунжута, отруби;
- белое мясо в отварном виде не чаще 1-2 раз в неделю;
- ржаной или отрубной хлеб;
- кисломолочные продукты пониженной кислотности – по одному виду в день в ограниченных количествах;
- крупы;
- растительные масла в качестве заправки для салатов, кроме подсолнечного;
- орехи и семечки – до 30 г в сутки в измельченном виде.
Под запрет попадают магазинные соки с добавками, сладкая газировка, энергетики, алкоголь, растворимый кофе, какао, жирное молоко. Особую пользу пациенту с болезнью Паркинсона принесут травяные чаи, отвар шиповника, натуральные соки и минеральная вода без газа. Также больному можно в ограниченных количествах употреблять нежирное молоко, отвар валерианы, компоты, кисели, морсы, зеленый чай. Любители натурального кофе не обязаны отказываться от этого напитка, если на то нет дополнительных показаний. Существует теория, согласно которой кофеин благотворно сказывается на состоянии тех отделов головного мозга, которые подверглись дегенерации. Допустимый объем энергетического состава рекомендуется согласовать с лечащим врачом.
Отваренные крупы и приготовленные из них каши должны составлять основу рациона пациента с болезнью Паркинсона. Под запрет попадает только перловка в силу плотности волокон. Ингредиенты лучше всего заливать кипятком и настаивать в термосе до готовности или отваривать. По возможности следует воздержаться от добавления молока даже в готовое блюдо. Оптимальная консистенция каш вязкая, однородная, без комков – масса, которую не обязательно долго жевать и легко проглотить. Включение в рацион круп позволяет улучшить работу кишечника, обеспечить организм медленными белками и микроэлементами, нормализовать работу головного мозга.
Ограничение вводится на продукты с грубой текстурой – репа, редис, редька. Остальные овощи можно употреблять свежими, в составе супов, в виде гарниров. Стручковая фасоль и шпинат содержат вещество, близкое по составу к дофамину, поэтому их рекомендуется употреблять круглый год.
Хорошее воздействие на организм оказывают бобовые.
Это может быть свежий зеленый горошек, отварные нут или фасоль.
Фрукты и ягоды богаты пектинами, витаминами, минералами, антиоксидантами. Их употребление в свежем виде приводит к насыщению организма биологически активными веществами, укреплению иммунитета, улучшению перистальтики кишечника. Напитки, приготовленные из отваренных свежих или замороженных ингредиентов, практически не уступают им в пользе. Главное, при их создании не использовать много сахара.
Голодание
Диета Паркинсона должна включать достаточное количество калорий. Но ученые отмечают, что голодание 2-4 дня позволяет активнее работать иммунной системе и стимулирует нейротрофический фактор мозга (позволяет образовываться новым нейронам).
Как используется голодание:
- Оно противопоказано на поздних стадиях заболевания;
- Применяется только при норме веса или избытке массы тела;
- Отличается кратковременностью – 1 день голода в неделю;
- Голодание разрешено после консультации с лечащим врачом.
Достоверных исследований о пользе голодания не проводилось. Выводы ученых основаны на изучении явления в небольших группах людей.
Продукты, запрещенные к употреблению
Из меню больного паркинсонизмом следует исключить жареные и копченые блюда, консервированные продукты, полуфабрикаты. Не рекомендуется готовить пищу сразу на несколько приемов, она каждый раз должна быть свежей.
Ингредиенты, которые надо полностью исключить из диетического рациона или хотя бы ограничить:
- животные жиры в виде красного мяса, колбас;
- простые углеводы – выпечка, сахар, шоколад;
- маргарин, сливочное масло;
- бульоны, приготовленные на мясе или костях;
- жирная кисломолочная и молочная продукция;
- готовая продукция с красителями, консервантами, усилителями вкуса и любыми химическими добавками. Особенно опасным для головного мозга считается глутамат натрия;
- крепкий черный чай, растворимый кофе.
Как совмещать лекарства и еду
Перерыв между едой и приемом медикамента в норме составляет 1,5-2 часа, но могут быть исключения.
Лекарство запивают большим количеством жидкости. Если оно вызывает тошноту, невролог может порекомендовать сменить график употребления средства или назначить симптоматическое лечение.
Употребление витаминов при Паркинсоне
С помощью сбалансированного и богатого витаминами рациона можно добиться снижения эмоционального и мышечного напряжения больного. Дополнительно такая пища укрепляет нервную систему и иммунитет, предупреждает развитие осложнений, снижает выраженность побочных эффектов от приема медикаментов.
Меню больного с Паркинсоном должно включать продукты, содержащие такие витамины:
- С – шиповник, болгарский перец, цветная капуста, цитрусы, клубника;
- В1 – овсянка, орехи, шпинат, картофель;
- В2 – шиповник, капуста, молочные продукты;
- В3 – злаки, отруби, арахис;
- В6 – зерновые, рыба, ягоды, бананы;
- В9 – темно-зеленые овощи, бобы;
- В12 – рыба, устрицы, морская капуста;
- Е – орехи, растительные масла, овсянка, морепродукты;
- D – кисломолочные продукты, растительные масла, морепродукты.
Если правильно и полноценно питаться, синдром Паркинсона будет прогрессировать медленнее, отодвигая момент наступления инвалидности. В случае невозможности достаточно наполнить рацион витаминами рекомендуется приступить к приему аптечных препаратов. Их перечень и дозировки устанавливает врач.
Советы по выбору и коррекции диеты
Болезнь Паркинсона сопровождается симптомами, дополнительно усугубляющими состояние пациента. Со многими из них можно справиться, внеся соответствующие коррективы в рацион. В частности, при проблемах с глотанием пищу следует употреблять максимально измельченную или полностью перетертую.
Надо минимизировать объем употребляемой соли, из-за которой жидкость задерживается в организме. В рацион вводят клюквенный морс, обладающий выраженным мочегонным эффектом. Избавлению от отеков также способствуют яблоки, сухофрукты, капуста. Дополнительно рекомендуется больше ходить, а в положении сидя поднимать ноги на стул или скамейку.
Упор в рационе делают на клетчатку, зерновые, фрукты и овощи. Обязательно поддержание питьевого режима. Дополнительно можно употреблять блюда с черносливом, растительные масла. Эффективность подхода повысится, если повысить физическую активность больного.
С отсутствием тяги к еде надо бороться комплексно. Пациенту показаны физические упражнения, прогулки на свежем воздухе. Блюда должны быть разнообразными, привлекательными, источающими приятный аромат. Меню для больного составляют с учетом его предпочтений. Калорийность рациона можно незначительно повысить, чтобы пациент наедался в те моменты, когда хочет есть.
С дискомфортом можно бороться с помощью лекарств, но сначала стоит попытаться внести несколько изменений в рацион. Еду не рекомендуется запивать. Не следует смешивать холодные и горячие блюда. После приема пищи надо выждать полчаса до чистки зубов или полоскания рта. От цитрусов или их сока лучше воздержаться.
❄ Эффективная профилактика
После многочисленных исследований ученые пришли к выводу, что развитие болезни Паркинсона проходит не без участия агрессивных свободных радикалов, которые постоянно вырабатываются в организме. Когда эти неустойчивые частицы испытывают нехватку электронов, то начинают отбирать их у ближайших молекул, разрушая тем самым клетки. Под их негативное воздействие попадают и те, что вырабатывают дофамин. Как противостоять этому процессу?
Лучшая профилактическая мера – это употребление продуктов, содержащих большое количество антиоксидантов. Самыми действенными признаны витамины С и Е, уровень которых у страдающих паркинсонизмом слишком низок, что лишний раз подтверждает предположения специалистов. Антиоксиданты защищают все важные структуры организма, отдавая свои электроны свободным радикалам, следовательно, их можно использовать для профилактики недуга.
С витамином С проще, ведь он присутствует во многих продуктах, но где брать витамин Е? Проблема состоит в том, что он содержится по большей части в жирных продуктах, например, в подсолнечном масле. Не пить же его из чашки. К счастью есть и другие способы увеличить потребление этого мощного антиоксиданта. В 20 граммах фундука (лесных орехов) примерно 4,5 МЕ данного витамина, что составляет 15% суточной нормы, а 3 столовые ложки пшеничных зародышей дадут 7 МЕ (23%).
Важно понимать, что вещества-антиоксиданты помогут предотвратить появление болезни Паркинсона, но исправить уже нанесенный вред они не способны.
Читайте также:


